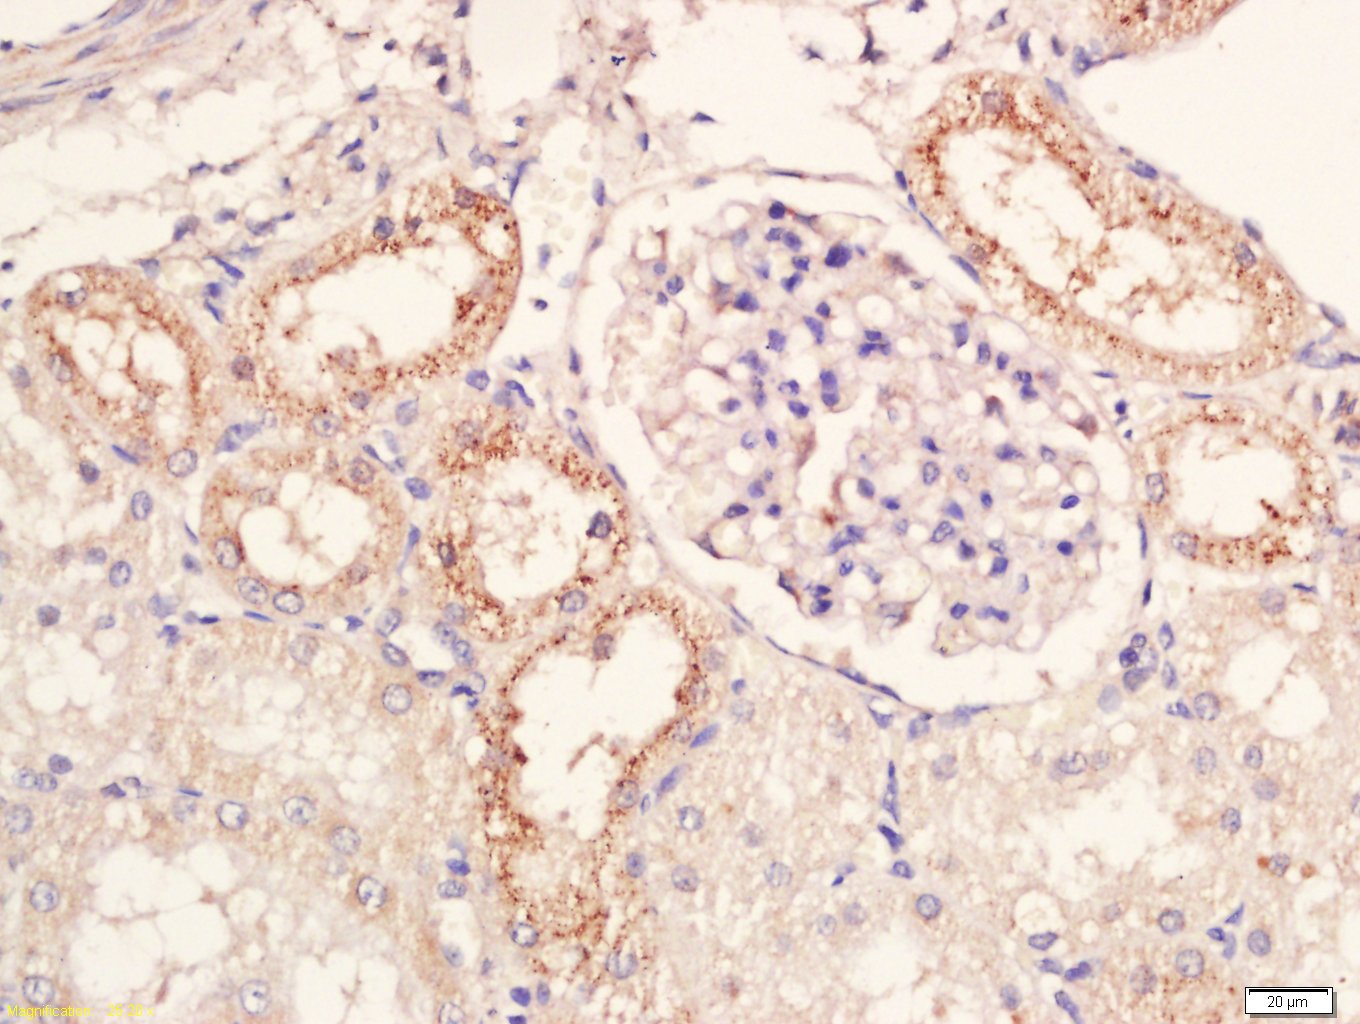
产品细节图片1

相关产品推荐更多 >

RNF169 Rabbit pAb(bs-9259R)-50ul/100ul/200ul
¥1180
hydrogen exchanger 3 Rabbit pAb, Biotin conjugated(bs-22547R-Bio)-100ul
¥2980
Aldolase A Rabbit pAb, RBITC conjugated(bs-2406R-RBITC)-100ul
¥2980
CD5 Rabbit pAb, AP conjugated(bs-10218R-AP)-100ul
¥2980
KAT5 / Tip60 Rabbit pAb(bs-13686R)-50ul/100ul/200ul
¥1180
万千商家帮你免费找货
0 人在求购买到急需产品
- 详细信息
- 文献和实验
- 技术资料
- 应用范围:
产品信息以Bioss网站为准
- 规格:
50ul/100ul/200ul
| 规格: | 50ul | 产品价格: | ¥1180.0 |
|---|---|---|---|
| 规格: | 100ul | 产品价格: | ¥1980.0 |
| 规格: | 200ul | 产品价格: | ¥2800.0 |
| 产品编号 | bs-20083R |
| 英文名称 | GPR106 Rabbit pAb |
| 中文名称 | G蛋白偶联受体106抗体 |
| 英文别名 | G protein coupled receptor 106; G-protein coupled receptor 106; G protein coupled receptor affecting testicular descent; GPR106; GPR-106; GREAT; INSL3R; Leucine rich repeat containing G protein coupled receptor 8; LGR8; Relaxin/insulin-like family peptide receptor 2; Relaxin family peptide receptor 2; Relaxin receptor 2; Relaxin receptor-2; RXFP 2; RXFP-2; RXFP2; RXFPR2; RXFP2_HUMAN; GPCR LGR8. |
| 产品应用 | IHC-P=1:100-500, IHC-F=1:100-500, IF=1:100-500 Not yet tested in other applications. |
| 交叉反应 | Rat (Human, Mouse, Dog, Pig, Cow, Horse, Rabbit, Sheep) |
| 抗体来源 | Rabbit |
| 免疫原 | KLH conjugated synthetic peptide derived from human GPR106 |
| 亚型 | IgG |
| 性状 | Liquid |
| 纯化方法 | affinity purified by Protein A |
| 克隆类型 | Polyclonal |
| 理论分子量 | 86 kDa |
| 浓度 | 1mg/ml |
| 储存液 | 0.01M TBS (pH7.4) with 1% BSA, 0.02% Proclin300 and 50% Glycerol. |
| 研究领域 | Neuroscience > Endocrine system > Gonadotrophic axis Neuroscience > Neurotransmission > Receptors / Channels > GPCR > More GPCR Signal Transduction > Signaling Pathway > G Protein Signaling > GPCR |
| 亚细胞定位 | Cell membrane; Multi-pass membrane protein. |
| 组织特异性 | Expressed mainly in the brain, kidney, muscle, testis, thyroid, uterus, peripheral blood cells and bone marrow. |
| 相似性 | Belongs to the G-protein coupled receptor 1 family.
Contains 1 LDL-receptor class A domain. Contains 10 LRR (leucine-rich) repeats. |
| 功能 | The activity of this relaxin receptor is mediated by G proteins leading to stimulation of adenylate cyclase and an increase of cAMP and may also be a receptor for Leydig insulin-like peptide. LGR8 has been reported in blood, bone marrow, brain, kidney, muscle, testis, thyroid, and uterus. |
| 保存条件 | Shipped at 4℃. Store at -20℃ for one year. Avoid repeated freeze/thaw cycles. |
| 注意事项 | This product as supplied is intended for research use only, not for use in human, therapeutic or diagnostic applications. |
| 背景资料 | This gene encodes a member of the GPCR (G protein-coupled, 7-transmembrane receptor) family. Mutations in this gene are associated with cryptorchidism. Alternatively spliced transcript variants encoding different isoforms have been found for this gene.[provided by RefSeq, Oct 2009]. |
| 应用 | 推荐稀释比例 |
| {IHC-P} | {1:100-500} |
| {IHC-F} | {1:100-500} |
| {IF} | {1:100-500} |
Antigen retrieval: citrate buffer ( 0.01M, pH 6.0 ), Boiling bathing for 15min; Block endogenous peroxidase by 3% Hydrogen peroxide for 30min; Blocking buffer (normal goat serum,C-0005) at 37℃ for 20 min;
Incubation: Anti-GPR106 Polyclonal Antibody, Unconjugated(bs-20083R) 1:200, overnight at 4°C, followed by conjugation to the secondary antibody(SP-0023) and DAB(C-0010) staining

Antigen retrieval: citrate buffer ( 0.01M, pH 6.0 ), Boiling bathing for 15min; Block endogenous peroxidase by 3% Hydrogen peroxide for 30min; Blocking buffer (normal goat serum,C-0005) at 37℃ for 20 min;
Incubation: Anti-GPR106 Polyclonal Antibody, Unconjugated(bs-20083R) 1:200, overnight at 4°C, followed by conjugation to the secondary antibody(SP-0023) and DAB(C-0010) staining

Antigen retrieval: citrate buffer ( 0.01M, pH 6.0 ), Boiling bathing for 15min; Block endogenous peroxidase by 3% Hydrogen peroxide for 30min; Blocking buffer (normal goat serum,C-0005) at 37℃ for 20 min;
Incubation: Anti-GPR106 Polyclonal Antibody, Unconjugated(bs-20083R) 1:200, overnight at 4°C, followed by conjugation to the secondary antibody(SP-0023) and DAB(C-0010) staining
风险提示:丁香通仅作为第三方平台,为商家信息发布提供平台空间。用户咨询产品时请注意保护个人信息及财产安全,合理判断,谨慎选购商品,商家和用户对交易行为负责。对于医疗器械类产品,请先查证核实企业经营资质和医疗器械产品注册证情况。
 文献和实验
文献和实验[IF={{ 7.267 }}] {Pan Z et al. Whole-genome sequences of 89 Chinese sheep suggest role of RXFP2 in the development of unique horn phenotype as response to semi-feralization. Gigascience. 2018 Apr 1;7(4).} {WB} {Sheep}
[IF={{ 4.8 }}] {Yawei GAO. et al. Sheep with Partial RXFP2 Knockout Exhibit Normal Horn Phenotype but Unilateral Cryptorchidism1. J INTEGR AGR. 2023 Nov;:} {WB} {Sheep}
= NAL), appears to form upon oxidative cyclization of the nonfluorescent 2:1 lysine-HNE Michael adduct-Schiff base cross-link (Scheme 1). Polyclonal antibody (PAb) to the NAL-HNE fluorophore was raised in rabbit and found to be highly specific
Flow Cytometric Analysis Of Bcl Family members
Description Cell Fixation, staining and flow cytometric analysis Procedure Cells (106) were washed twice in FACS buffer (phosphate buffered saline PBS pH 7.4 containing 2% fetal calf serum(FCS) and 0.02% NaN3) and resuspended in 250ƒY´l
Steady State ATPase Assays Coupled Enzyme System
from Rabbit Muscle in 50% glycerol) Procedure 1. Assemble microtubules for assays. E.g., 58 µL of 50 µM MTs = 50 µL 5.8 mg/mL tubulin + 0.5 µL 100 mM Mg・GTP, incubate for 30-60 min at 37°C
 技术资料
技术资料暂无技术资料 索取技术资料






